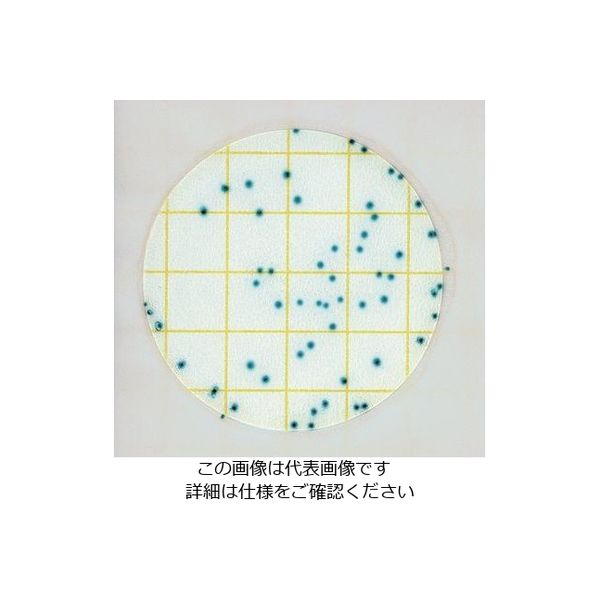
ネオジェンジャパン ペトリフィルム(TM)培地 (大腸菌選択用/25枚×2袋

マイストア
変更
お店で受け取る
(送料無料)
配送する
納期目安:
2026.01.15 8:32頃のお届け予定です。
決済方法が、クレジット、代金引換の場合に限ります。その他の決済方法の場合はこちらをご確認ください。
※土・日・祝日の注文の場合や在庫状況によって、商品のお届けにお時間をいただく場合がございます。
Bennymori専用ページ クイーンマットレス(NスリープハードH1-02CR VB) | ニトリネット【公式の詳細情報
クイーンマットレス(NスリープハードH1-02CR VB) | ニトリネット【公式。EBiS303イベントホールご利用事例/ 2024年9月28日(土)、EBiS303。製品情報:Class KR ['10加速騒音規制対応モデル] N713103 | 柿本改。製品情報:Class KR センター付 ['10加速騒音規制対応モデル] N713118。。バーベルプレート4枚 15kg2枚 20kg2枚
ベストセラーランキングです
近くの売り場の商品
カスタマーレビュー
オススメ度 4.7点
現在、6707件のレビューが投稿されています。

![製品情報:Class KR ['10加速騒音規制対応モデル] N713103 | 柿本改 製品情報:Class KR ['10加速騒音規制対応モデル] N713103 | 柿本改](https://www.kakimotoracing.co.jp/products/images/productmodel/1728.productmodelimage.image_1.png)
![製品情報:Class KR センター付 ['10加速騒音規制対応モデル] N713118 製品情報:Class KR センター付 ['10加速騒音規制対応モデル] N713118](https://i.ytimg.com/vi/1m28CD-DQYc/hqdefault.jpg)














